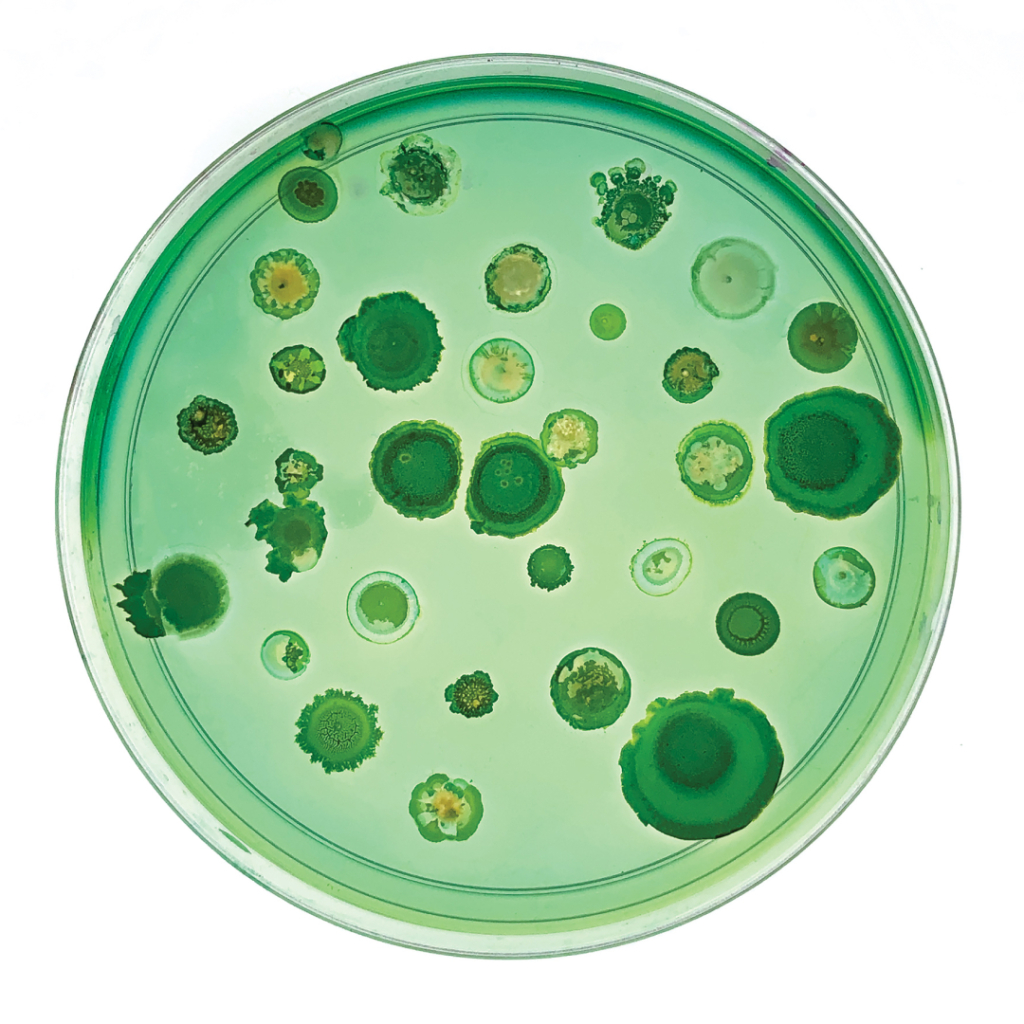
Petri dish with various green bacterial and fungal colonies growing on agar.
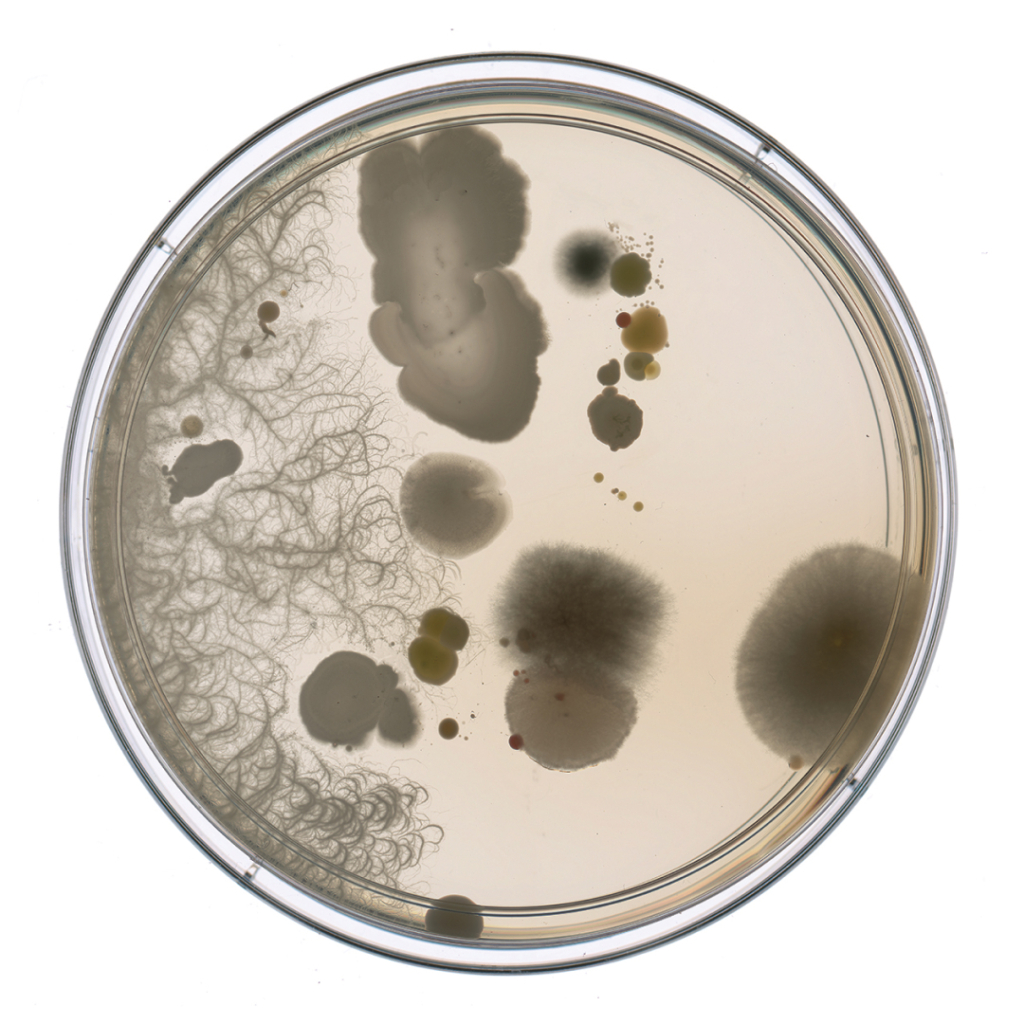
Petri dish with various bacterial and fungal colonies growing on agar medium.

There’s an invisible world in, on, and all around us. In celebration of the release of bio-artist Tal Danino’s book 𝘉𝘦𝘢𝘶𝘵𝘪𝘧𝘶𝘭 𝘉𝘢𝘤𝘵𝘦𝘳𝘪𝘢, here is a selection of stunning microbes to feast your eyes on.

Bacteria are beautiful.
With swirling patterns, ringed formations, vast colonies growing outward in intricate wisps, these petri dishes look, at first glance, akin to Earth’s topography or even like faraway galaxies and nebulas in space. But this is the invisible world of microbes, a micro-universe of microscopic organisms (mostly bacteria) that can be cultivated in a lab, programmed, manipulated, studied, and even turned into stunning, vibrant works of art.
Enter Tal Danino. Tal is an Associate Professor at Columbia University and directs the interdisciplinary Synthetic Biological Systems Laboratory where he engineers some of the smallest, invisible forms of life (microbes) and cultures them into art. He also leads the research at the Danino Lab, where a team of scientists use synthetic biology to engineer living medicines with a focus on programming microbes for cancer therapy.
These captivating pieces, created in petri dishes (often no larger than 100 millimeters), have been curated and put into print in his new book Beautiful Bacteria.
We invite you to get a copy for your home—available now from your favorite bookstore—where you can explore the hundreds of samples of microbial bio-art Tal has created, but also enjoy a selection of some of our favorites from his body of work below.
As artist Vik Muniz put it in his forward of the book: “Beautiful Bacteria is a seductive guide to our world’s most ubiquitous co-existing lifeforms. [It] is a book that allows humans to connect to and learn from something that has been everywhere since the dawn of life—but has remained unnoticed largely because it was never seen as a form of beauty.”

Science with us—nerdy reads for your inbox biome1
1By signing up, you consent to receive Med-Lock emails.
1. Bacterial Colonies

Multiple colonies of Escherichia coli (E. coli) cultivated in a petri dish. This dish was stained with dyes and preserved by drying it. A bacterial colony refers to a group of bacteria derived from the same “mother” cell. This means that a single cell reproduces, giving rise to a group of genetically identical cells that form a mass, a.k.a. a bacterial colony.
2. Drain Water

Bacteria from drain water, grown on blood agar to help isolate fastidious organisms. The colonies’ colors, morphologies, and sizes hint at the identification of about 10 different species seen here.
3. Coworkers
A multitude of distinct bacterial species sampled from 400 coworkers, grown in petri dishes, then stained with artistic dyes to add color and scientific dyes to highlight colonies and patterns. The species you see here are predominantly from the skin.
4. Bioengineered Bacteria

Proteus mirabilis has a swarming clock-like timing and its consistency suggests application as a recording system, similar to the way a growing tree records information in the rings of its trunk. P. mirabilis can be engineered to sense various stimuli such as copper, which is a water contaminant, and change its swarming process. The end result, stained for visualization, is a system that can visibly “write” information about levels of contaminant onto a petri dish. Here, you see a collection of Proteus mirabilis strains grown in petri dishes and dyed with various colors. Each has been engineered to produce additional proteins that influence the type of pattern produced.
5. Sand

Paenibacillus latus isolated from sand and grown in a petri dish forming a complex colony structure.
6. Sauerkraut

This isolate from sauerkraut was grown for two days, revealing densely populated, wrinkled colonies with elevated growth.
7. A Toddler’s Hand
A sample collected from a toddler’s hand. The colors, textures, and shape demonstrate diverse species present. Towards the left, a Bacillus species grows filamentously across the petri dish.
Credit: Tal Danino + Soonhee Moon (The Danino Lab)



















